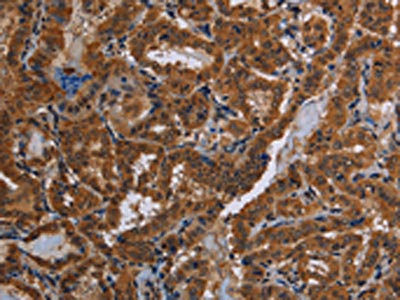

CYBB Antibody
-
中文名稱:CYBB兔多克隆抗體
-
貨號:CSB-PA176464
-
規格:¥1100
-
圖片:
-
The image on the left is immunohistochemistry of paraffin-embedded Human brain tissue using CSB-PA176464(CYBB Antibody) at dilution 1/40, on the right is treated with synthetic peptide. (Original magnification: ×200)
-
The image on the left is immunohistochemistry of paraffin-embedded Human thyroid cancer tissue using CSB-PA176464(CYBB Antibody) at dilution 1/40, on the right is treated with synthetic peptide. (Original magnification: ×200)
-
-
其他:
產品詳情
-
Uniprot No.:
-
基因名:
-
別名:AMCBX2 antibody; CGD antibody; CGD91-phox antibody; CY24B_HUMAN antibody; CYBB antibody; Cytochrome b 245; beta polypeptide antibody; Cytochrome b(558) beta chain antibody; Cytochrome b(558) subunit beta antibody; Cytochrome b-245 heavy chain antibody; Cytochrome b558 subunit beta antibody; GP91 PHOX antibody; gp91-1 antibody; gp91-phox antibody; GP91PHOX antibody; Heme-binding membrane glycoprotein gp91phox antibody; NADPH oxidase 2 antibody; Neutrophil cytochrome b 91 kDa polypeptide antibody; NOX2 antibody; p22 phagocyte B-cytochrome antibody; P91 PHOX antibody; p91-PHOX antibody; Superoxide-generating NADPH oxidase heavy chain subunit antibody
-
宿主:Rabbit
-
反應種屬:Human,Mouse
-
免疫原:Synthetic peptide of Human CYBB
-
免疫原種屬:Homo sapiens (Human)
-
標記方式:Non-conjugated
-
抗體亞型:IgG
-
純化方式:Antigen affinity purification
-
濃度:It differs from different batches. Please contact us to confirm it.
-
保存緩沖液:-20°C, pH7.4 PBS, 0.05% NaN3, 40% Glycerol
-
產品提供形式:Liquid
-
應用范圍:ELISA,IHC
-
推薦稀釋比:
Application Recommended Dilution ELISA 1:2000-1:5000 IHC 1:50-1:200 -
Protocols:
-
儲存條件:Upon receipt, store at -20°C or -80°C. Avoid repeated freeze.
-
貨期:Basically, we can dispatch the products out in 1-3 working days after receiving your orders. Delivery time maybe differs from different purchasing way or location, please kindly consult your local distributors for specific delivery time.
-
用途:For Research Use Only. Not for use in diagnostic or therapeutic procedures.
相關產品
靶點詳情
-
功能:Critical component of the membrane-bound oxidase of phagocytes that generates superoxide. It is the terminal component of a respiratory chain that transfers single electrons from cytoplasmic NADPH across the plasma membrane to molecular oxygen on the exterior. Also functions as a voltage-gated proton channel that mediates the H(+) currents of resting phagocytes. It participates in the regulation of cellular pH and is blocked by zinc.
-
基因功能參考文獻:
- platelet aggregation resulted to be higher in patients with atrial fibrillation carrying the C2238 ANP gene variant with respect to non-carriers. In conclusions, C2238/alphaANP promotes platelet aggregation through the activation of Nox2 and the reduction of cAMP. PMID: 28630469
- These results suggest the specific involvement of Nox4 and Nox2 subunits as physiologically relevant endothelial sources of H2O2 generation that contribute to the endothelium-dependent vasodilatation of renal arteries and therefore have a protective role in kidney vasculature. PMID: 30125808
- The activity of Nox2 is lowered in neutrophils of untreated hypercholesterolemic patients. Finally oxysterols (25-hydroxy-cholesterol or 5alpha, 6alpha - epoxy-cholesterol) do not induce effects different from that of non-oxidized cholesterol. PMID: 29103982
- indicated that miR-27b exerted its protective role in retinal pigment epithelium cells under PDGF-BB stimulation was partially through regulation of Nox2 PMID: 29858119
- Findings show that under elevated glucose concentration, NOX2 is activated by SMIT1 triggering ROS production in the heart. PMID: 28128227
- Human post-mortem and animal studies have identified elevated NOX2 and NOX4 levels in the injured brain, suggesting that these two NOXs are involved in the pathogenesis of Traumatic brain injury (TBI) PMID: 29571125
- To further elucidate the mAb 7D5 epitope on human gp91(phox) , chimeric DNA expressed human and mouse gp91(phox) recombinant protein were constructed. The fusion proteins were immunostained for mAb 7D5 and analyzed by FACS and western blot analysis. PMID: 29573449
- Phorbol 12-myristate-13-acetate-stimulated NOX2-NIS (NOX-specific Insertion Sequence) phosphorylation by ATM kinase causes a dynamic switch that deactivates NOX2 activity. This downregulation may be defective in NOX2-NIS3 mutant because of the absence of Ser486. PMID: 28916473
- This study identifies one novel mutation in the IL2RG gene and another, previously described mutation in the CYBB genes. It is the first report establishing a diagnosis of X-SCID and X-CGD using WES in Chinese patients. PMID: 29388853
- In a male patient suffering from X-linked chronic granulomatous disease (CGD) we found a c.389G>T mutation in exon 5 of the CYBB gene. PMID: 28886419
- The potency of RTK inhibition by BJ-1301 was lower than that of sunitinib (a multi-RTK inhibitor), but the inhibition of downstream signaling pathways (e.g., ROS generation) and subsequent biological changes (e.g., NOX2 induction) by BJ-1301 was superior PMID: 28536313
- Translated to human pathophysiology, we found increased gp91(phox) expression in endomyocardial biopsies of Alcoholic cardiomyopathy (ACM) patients. In conclusion, ACM is promoted by ACA-driven mitochondrial dysfunction and can be improved by ablation of NOX2/gp91(phox). NOX2/gp91(phox) therefore might be a potential pharmacological target to treat ACM. PMID: 27624556
- We demonstrated that small interfering RNA (siRNA)-mediated knockdown of PRR, Nox2 and Nox4 significantly reduced the HG-induced stimulation of VEGF. On the other hand, Nox4 overexpression significantly potentiated PRR-induced stimulation of VEGF under hyperglycemia in ARPE-19 cells. PMID: 28840773
- NOX2 isoform in blood samples has been considered as biomarker of disease severity and treatment efficacy in neurodegenerative disease. (Review) PMID: 28811143
- Study demonstrates that there is no increase of NOX2 expression in schizophrenic patients. Unexpectedly, however, the study found that NOX2 expression was decreased in patients with bipolar disorder. PMID: 28809856
- Hyperinsulinemia modulates arteriolar flow-induced dilation via Nox2-mediated superoxide production. PMID: 28600985
- this study shows that aging-associated metabolic disorder induces Nox2 activation and oxidative damage of endothelial function PMID: 28499911
- Results show that Nox2 knockdown attenuated HIV-1 Tat-induced HDAC6 expression and subsequent expression of chemokines. Also, the data provide evidence that HDAC6 mediates HIV-1 Tat-induced reactive oxygen species generation by regulating the activity and expression of Nox2-based NADPH oxidase in astrocytes, and demonstrate the existence of a crosstalk between HDAC6 and NADPH oxidase in HIV-1 Tat-stimulated astrocytes. PMID: 28499252
- Porphyromonas gingivalis modulates the danger signal eATP-induced NOX2 signaling and also induces host glutathione synthesis to likely avoid HOCl mediated clearance. PMID: 28725637
- the increased oxidative stress was mediated by nox2 dependent reactive oxygen species overproduction that could downregulate whole-cell K(+) currents PMID: 28077855
- Nox2 activity efficiently contributes to the mechanism of oxidative stress-induced increase in premature aging conferred by doxorubicin. The importance of modulation of Nox2 in human EPCs could reveal a useful tool to restore endothelial progenitor cells physiological function and properties. PMID: 27181082
- We examined the pattern of NOX expression in spinal cords of patients and mouse models of ALS and analyzed the impact of genetic deletion of the NOX1 and 2 isoforms as well as pharmacological NOX inhibition in the SOD1(G93A) ALS mouse model.In contrast to previous publications, survival of SOD1(G93A) mice was not modified upon breeding with constitutive NOX1 and NOX2 deficient mice. PMID: 27212019
- Recent studies reveal that AKT2-NOX2 signaling has critical roles in Ca mobilization, ROS generation, degranulation, and control of the ligand-binding function of cell surface molecules, thereby promoting heterotypic cell-cell interactions in thromboinflammation. PMID: 28650848
- Study demonstrate that Nox2 signaling via inactivation of phosphatase and tensin homolog and activation of the PI3K/Akt pathway leads to membrane ruffling and macropinocytosis. PMID: 27488058
- Our findings indicate that Nox2 deficiency results in exaggerated experimental asthma, which is caused by enhanced Th2 effector function in a T-cell-intrinsic manner. PMID: 27253713
- Finally, overexpression of miR34a in EBNA1-expressing SNU719 cells induced typical apoptosis, suggesting that reactivation of miR34a in EBNA1-expressing gastric cancer cells could be a strategy for treatment of EBV-infected gastric cancer cells. PMID: 29061308
- NOX2 expression was significantly higher in the cortex of asphyctic suicide subjects than in non-suicidal asphyxia and controls. PMID: 27187235
- Acute myeloid leukemia cells -derived NOX2 drives transfer of mitochondria via the generation of superoxide. PMID: 28733324
- NOX2, NOX4, and mitochondrial-derived reactive oxygen species contribute to angiopoietin-1 signaling and angiogenic responses in endothelial cells. PMID: 28351775
- PFK-2 seems to be a strategic element that links NADPH oxidase activation and glycolysis modulation, and, as such, is proposed as a potential therapeutic target in inflammatory diseases. PMID: 27799347
- data support NOX2 as a critical component of the suppressive machinery of CD8 Tregs and suggest that repairing NOX2 deficiency in these cells may protect older individuals from tissue-destructive inflammatory disease, such as large-vessel vasculitis. PMID: 27088800
- CD8+ T cells in close contact with target T cells release NADPH oxidase 2-containing microvesicles that inhibit TCR activation by elevating ROS and thereby reducing phosphorylation of the TCR-associated kinase ZAP70. PMID: 27088803
- Thioredoxin attenuates oxidized low-density lipoprotein induced oxidative stress in human umbilical vein endothelial cells by reducing NOX2-NOX4 activity. PMID: 28688762
- Nox4-derived H2O2 in part activates Nox2 to increase mitochondrial ROS via pSer36-p66Shc, thereby enhancing VEGFR2 signaling and angiogenesis in endothelial cells. PMID: 28424170
- Cytochrome b558 also traffics from a lysosomal pool to phagosomes and this is required to replenish oxidatively damaged NOX2. PMID: 28202687
- Nox4 should contribute to the pathological processes insubarachnoid hemorrhage(SAH)-induced early brain injury (EBI), and there was not an overlay effect of Nox2 inhibition and Nox4 inhibition on preventing SAH-induced EBI. PMID: 28330417
- NADPH oxidase promotes Parkinsonian phenotypes by impairing autophagic flux in an mTORC1-independent fashion in a cellular model of Parkinson's disease PMID: 26960433
- TLR4- and TLR2-induced IRAK-ERK pathway cross-talks with p67phox-Nox-2 for reactive oxygen species generation, thus regulating IL-1beta transcription and processing in monocytic cells. PMID: 26320741
- NOX2 levels were higher in those patients infected with H. pylori irrespective of the virulence factors than those uninfected patients. PMID: 27048452
- This study demonstrates that one of the critical mechanisms underlying curcumin inhibiting heat-induced apoptosis is through suppressing NADPH Oxidase 2 and activating the Akt/mTOR signaling pathway in bronchial epithelial cells. PMID: 28478460
- Skeletal muscle protein expression of the NADPH oxidase subunits p22(phox), p47(phox), and p67(phox) was increased in obese relative to lean subjects, where p22(phox) and p67(phox) expression was attenuated by exercise training in obese subjects. PMID: 27765769
- A mutation in CYBB gene encoding gp91-phox located on chromosome Xp21.1, leads to X-linked Chronic granulomatous disease PMID: 27917630
- NOX-2 probably contributes to extracellular matrix loss by the activation of hyaluronidase through acidification. PMID: 28070636
- A novel regulatory mechanism for SNAP23-dependent mast cell activation of T. vaginalis-secreted LTB4 involving surface trafficking of BLT1. PMID: 27795355
- The ROS levels of the study group decreased obviously before irradiation (P<0.01), however, the radiation-induced ROS of the study group was at a high level even when irradiation had been terminated for 2 h (P<0.01). Moreover, NOX2 and NOX4 levels and total SOD activity decreased (P<0.01), while the levels of SOD1 were stably maintained (P>0.05). PMID: 28260074
- The authors report the absence of an oxidative burst in the phagocytes of the patient with a novel missense c.1226C > A mutation in the CYBB gene resulting in p.A409E. PMID: 27666509
- alkali burns markedly upregulated the transcription and expression of Nox2 and Nox4 in human or mouse corneas. PMID: 27221536
- These findings provide novel insights into oleanolic acid-induced inhibition of rectal cancer cell proliferation and highlight NOX2/ROS/HIF-1alpha axis as a novel therapeutic target for the treatment of rectal cancer. PMID: 27938946
- NOX2 induces antigen release from endosomes for cross-presentation by direct oxidation of endosomal lipids. PMID: 26907999
- Critical role of the Mac1/NOX2 pathway in mediating reactive microgliosis-generated chronic neuroinflammation and progressive neurodegeneration PMID: 26498406
顯示更多
收起更多
-
相關疾病:Granulomatous disease, chronic, X-linked (CGD); Immunodeficiency 34 (IMD34)
-
亞細胞定位:Cell membrane; Multi-pass membrane protein.
-
組織特異性:Detected in neutrophils (at protein level).
-
數據庫鏈接:
Most popular with customers
-
-
YWHAB Recombinant Monoclonal Antibody
Applications: ELISA, WB, IHC, IF, FC
Species Reactivity: Human, Mouse, Rat
-
Phospho-YAP1 (S127) Recombinant Monoclonal Antibody
Applications: ELISA, WB, IHC
Species Reactivity: Human
-
-
-
-
-